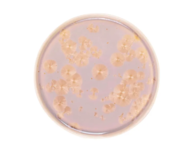
Royal Charm     , 21 ,
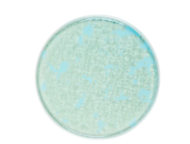
Royal Charm     , 26 ,
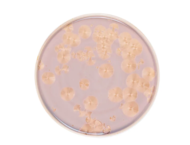
Royal Charm     , 26 ,

Тарелки Royal Charm
Великолепное качество и продуманный дизайн стали визитной карточкой Royal Charm. Красота и функциональность многократно подтверждена экспертами. Покупая Тарелки Royal Charm вы можете быть уверены, что приобрели высококачественный товар, изготовленный из экологически чистых материалов. Использование современных технологий производства гарантирует длительный срок службы изделий.
Почему покупают в Суперпосуде :
Почему покупают в Суперпосуде
Только оригинальная продукция
Гарантия минимальной цены
Подтвердим заказ
за 10 минут
за 10 минут
Нам можно доверять
работаем с 2009 года
работаем с 2009 года
Доставка по всей России
Обмен и возврат
в течение 30 дней
в течение 30 дней
Оплата наличными и банковскими картами
Вернем до 10% стоимости покупки на бонусный счет